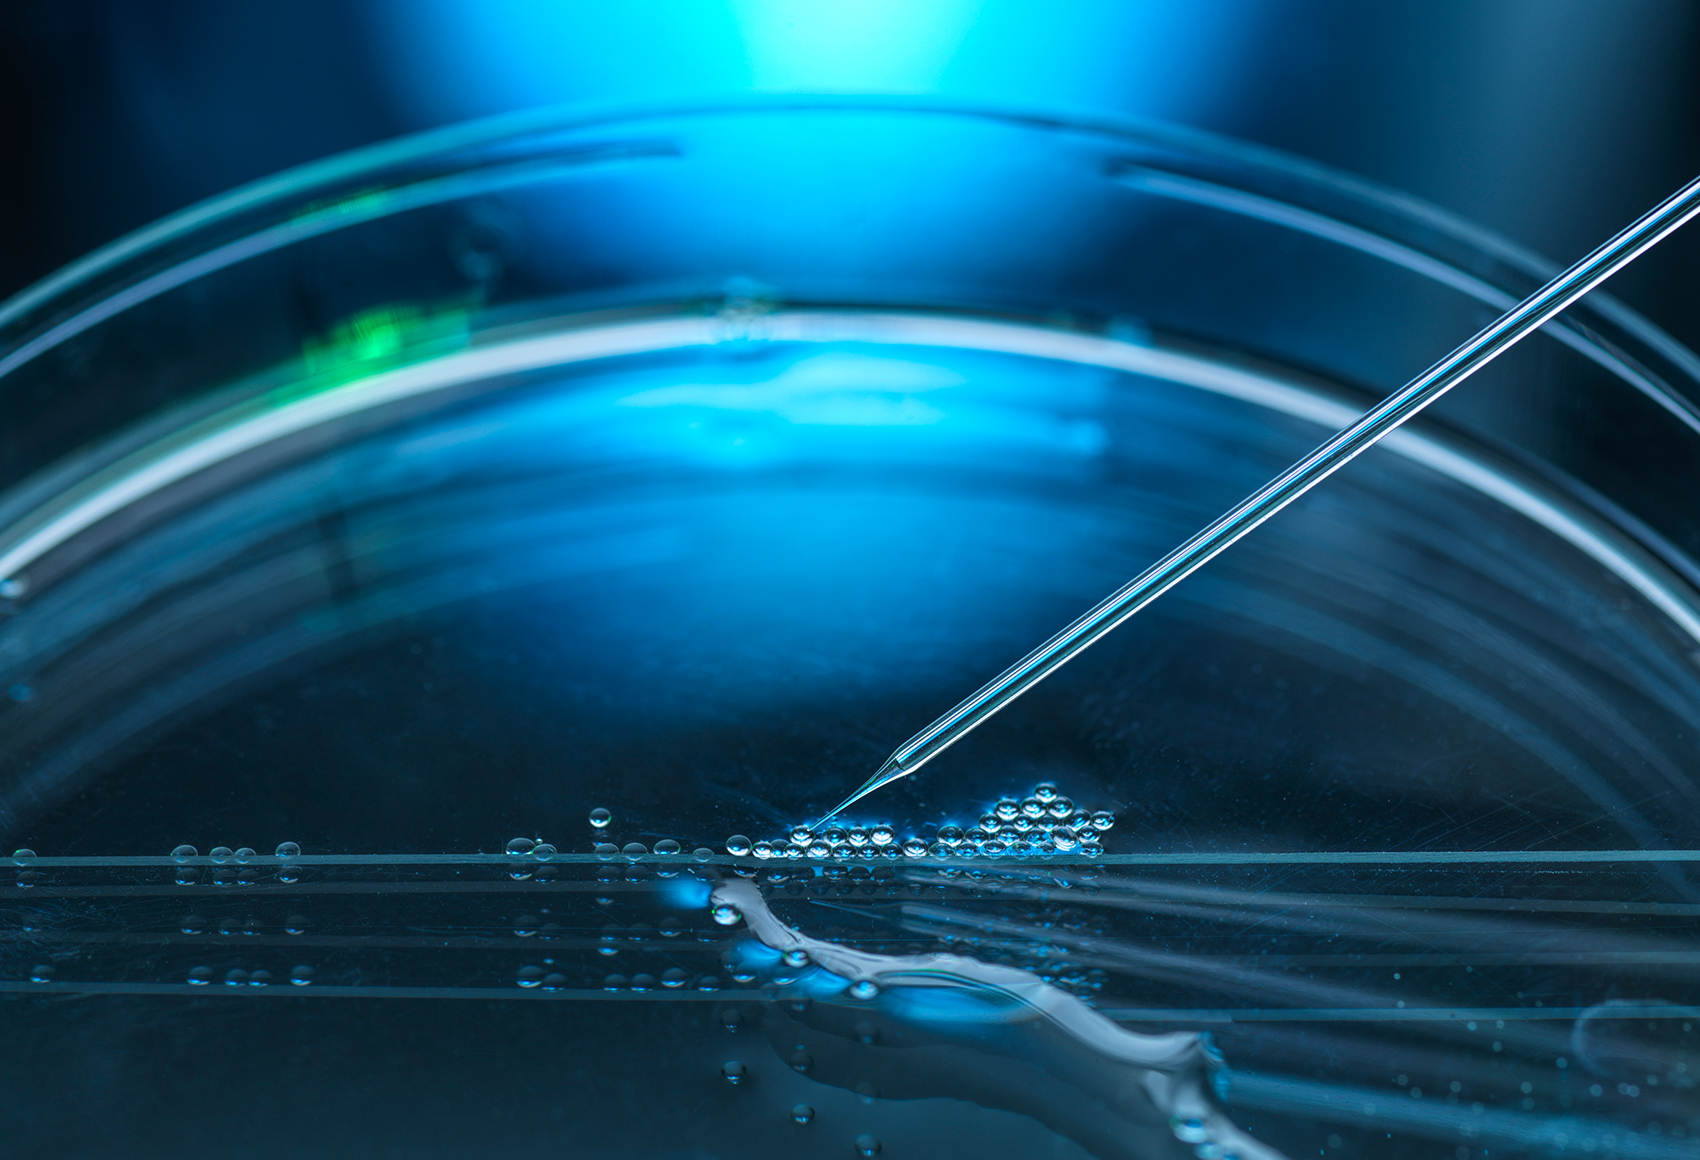
Guide to Biosimilars

In continuation of Goodwin’s previous webinar series concerning biosimilars, our 2023-2024 webinar series will dive deep into some of the key topics pertaining to this burgeoning industry and corresponding area of law.
Stay tuned for more details below, including registration information for upcoming webinars.
Please note that our webinar and event recordings are for informational purposes only. CLE credit is only available for our guests attending live webinars and other specified events.
September 13, 2023 | 12:00 PM – 1:00 PM EDT
Successfully developing and commercializing a biosimilar is a complex and expensive process. This webinar provided a broad overview of important strategic considerations that biosimilar makers should take into account before submitting an aBLA to increase the odds of a successful launch. Topics covered include the 271(e) Safe Harbor, peremptory challenges, labelling and timing considerations, and competitive intelligence.
Speakers:
Naomi Birbach
Josh Weinger
Alison Siedor
October 12, 2023 | 12:00 PM – 1:00 PM EDT
The world of biosimilar litigation is back in full swing with several BPCIA lawsuits currently pending. This webinar covered strategies and considerations during pre-litigation disclosures under the BPCIA (the so-called “patent dance”) and in BPCIA litigation with a particular focus on what we have learned from the most recent wave of BPCIA litigations. We discussed considerations for the timing of filing an aBLA, strategies for disclosure during the patent dance and early litigation, and key issues during BPCIA litigation from a reference product sponsor and biosimilar applicant perspective.
Speakers:
Elaine Blais
Natasha Daughtrey
Alexandra Valenti
November 14, 2023 | 12:00 PM – 1:00 PM EDT
In an update to Goodwin’s May 2020 webinar regarding Biosimilar challenges at the PTAB, this webinar explored topics including:
- Evolving trends of biologic patent challenges at the PTAB;
- Strategic considerations for biosimilar manufacturers;
- Lessons learned from recent filings.
Linnea Cipriano
James Breen
Christine Potkay
More details to come!
Speakers:
Tiffany Mahmood
Kevin DeJong
Contacts
- /en/people/b/bian-yoko

Yoko J. Bian, Ph.D.
Science Law ClerkIP Litigation - /en/people/b/birbach-naomi

Naomi Birbach
Partner - /en/people/b/blais-elaine-herrmann

Elaine Herrmann Blais
PartnerCo-Chair, Intellectual Property Litigation - /en/people/b/breen-james

James Breen
Associate - /en/people/c/cipriano-linnea

Linnea P. Cipriano
Partner - /en/people/d/daughtrey-natasha

Natasha E. Daughtrey
Partner